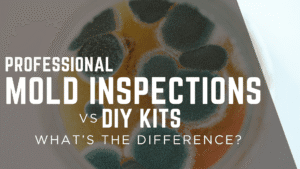

Commercial Property Inspections — Why Businesses in Northwest Tennessee Trust Certified Inspectors
Whether you’re investing in a retail storefront in Martin, leasing a warehouse in Union City, or managing an office complex in Dresden, your property is more than a building — it’s a business asset. And like any major investment, it deserves careful evaluation before you sign on the dotted line.